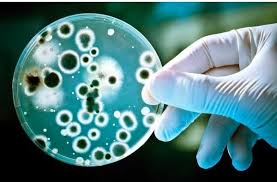
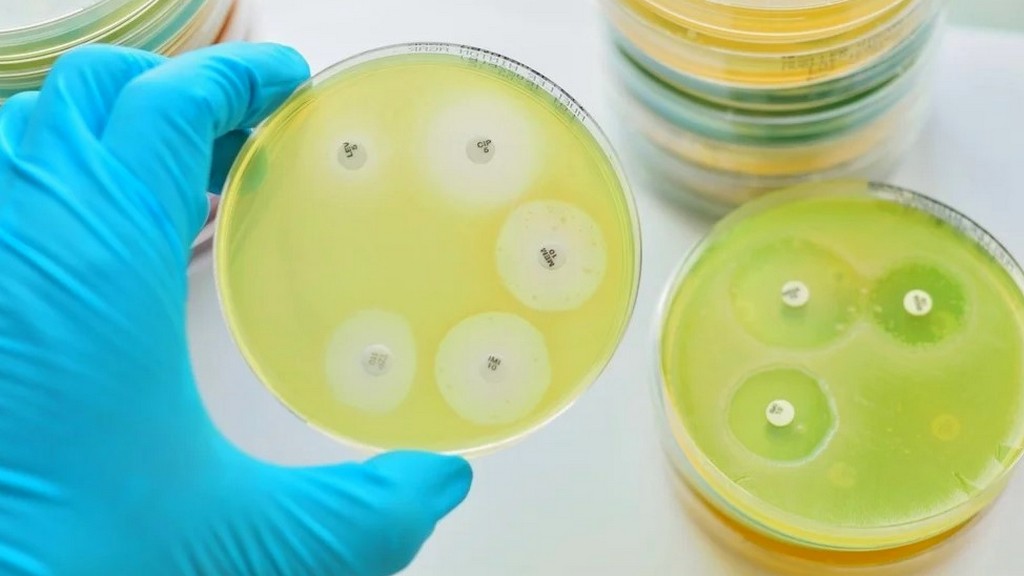

Mikrobiologik va bakterologik tekshirishlar
Murojaat uchun Tel: +998 97 910 56 27
Bozorboy Elmurodov
Murojaat uchun Tel: +998 90 743 14 88
Nurali Navruzov
IFA, PZR, ELISA
Murojaat uchun Tel: +998 97 925 93 96
Sobir Abdalimov

Diagnostika
Murojaat uchun Tel: +998 91 529 75 89
Rano Ismatova

Gelmintologik tekshirishlar
Murojaat uchun Tel: +998 93 997 88 79
Jasur Isayev

Parazitologik tekshirishlar
Murojaat uchun Tel: +998 93 991 60 67
Faxriddin Pulotov

Biokimyoviy tekshirishlar
Murojaat uchun Tel: +998 94 531 77 33
Nazira Karimova

Epizotiyaga qarshi kurash
Murojaat uchun Tel: +998 50 075 55 88
Azamat Ulug’muradov

Preparatlarga nisbatan sezuvchanlik va preparatlarni sinovdan o’tkazish
Murojaat uchun Tel: +998 93 348 39 79
Soxib Tursunov

Toksikologiya
Murojaat uchun Tel: +998 91 552 94 74
Mashrab Isayev


Patanatomik va patomorfologik tekshirishlar
Murojaat uchun Tel: +998 93 330 32 50
Olim Djurayev



